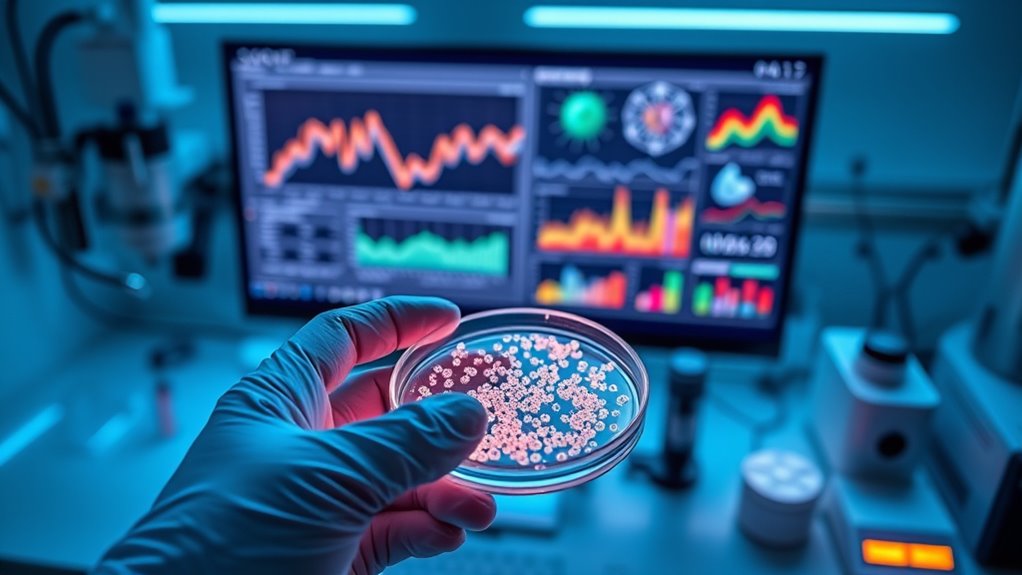
ai enhances nanomedicine evaluation

Using AI to track nanomedicine efficacy allows you to analyze complex imaging, blood flow, and molecular data in real time. It helps predict how nanoparticles distribute across tissues, monitor their activity during treatment, and personalize therapies for better outcomes. AI also supports dynamic adjustments, enhancing treatment precision and reducing side effects. If you want to discover how these innovative tools can revolutionize nanoparticle tracking and optimize your approaches, there’s more to explore ahead.
Key Takeaways
- AI analyzes imaging, molecular, and blood data to monitor nanoparticle distribution and activity in real-time.
- Predictive models forecast nanomedicine efficacy and side effects tailored to individual patients.
- Integrating AI with sensors enables dynamic feedback for ongoing treatment adjustments.
- Automated data processing accelerates understanding of nanoparticle behavior during therapy.
- AI-driven insights support early detection of treatment issues, optimizing nanomedicine efficacy.
Advancements in artificial intelligence are transforming how we evaluate the effectiveness of nanomedicine treatments. One of the key areas where AI makes a significant impact is in understanding nanoparticle biodistribution. When you administer nanomedicine, knowing where the nanoparticles travel within the body is essential. Traditional methods involve invasive imaging and tissue sampling, which can be time-consuming and sometimes imprecise. Now, with AI-powered tools, you can analyze complex data sets faster and more accurately. AI algorithms process imaging results, blood flow data, and molecular markers to predict how nanoparticles distribute across different tissues. This insight allows you to refine nanomedicine design, ensuring the particles reach their intended targets while minimizing off-target effects. By leveraging AI for nanoparticle biodistribution analysis, you gain a more complete understanding of how your treatment behaves in vivo, which accelerates the development process and enhances safety profiles. Additionally, increased data processing capabilities enable more comprehensive analysis, leading to better-informed decisions in treatment development.
AI predictive modeling takes this a step further by enabling you to forecast how nanomedicine will perform in individual patients. Instead of relying solely on generalized data, you can input patient-specific variables—such as genetics, metabolic rates, and immune responses—into AI models. These models then generate predictions on nanoparticle behavior, therapeutic efficacy, and potential side effects. This personalized approach helps you optimize dosing strategies and treatment protocols, increasing the likelihood of successful outcomes. As AI models learn from vast datasets, they continuously improve their accuracy, giving you a powerful tool to tailor nanomedicine therapies to each patient’s unique physiology. The predictive power of AI also supports early decision-making, highlighting potential issues before they manifest clinically, which saves time and resources.
Furthermore, integrating AI with nanoparticle biodistribution studies enhances your ability to monitor treatment progress in real-time. Machine learning algorithms can analyze imaging and sensor data collected during therapy, providing ongoing assessments of nanoparticle localization and activity. This dynamic feedback loop allows you to adjust treatment plans promptly, improving efficacy and reducing adverse effects. As AI-driven predictive modeling becomes more sophisticated, it will increasingly serve as an essential component in clinical trials and routine medical practice, helping you make data-driven decisions with confidence. Overall, these technological advancements empower you to track nanomedicine efficacy more precisely, accelerating the path from research to real-world application and ultimately improving patient outcomes.
Frequently Asked Questions
How Does AI Improve Nanomedicine Delivery Precision?
AI improves nanomedicine delivery precision by enabling targeted delivery, ensuring the medicine reaches specific cells or tissues. It analyzes complex data to optimize nanoparticle design and delivery routes, increasing diagnostic accuracy. You benefit from faster, more accurate treatments that minimize side effects and improve outcomes. By continuously learning from new data, AI helps refine nanomedicine strategies, making therapies more effective and personalized for each patient’s unique needs.
What Are the Challenges in Integrating AI With Nanomedicine Tracking?
You face challenges integrating AI with nanomedicine tracking due to regulatory hurdles and data standardization issues. Regulations vary across regions, slowing approval processes and requiring rigorous validation. Additionally, inconsistent data formats hinder seamless AI analysis, making it tough to develop reliable models. Overcoming these obstacles demands collaboration among scientists, regulators, and industry to establish common standards and streamlined pathways, ensuring safe and effective nanomedicine advancements.
How Does AI Handle Data Privacy in Nanomedicine Research?
AI handles data privacy in nanomedicine research by implementing data encryption to protect sensitive information. It also adheres to privacy regulations, ensuring compliance with legal standards like GDPR or HIPAA. You can trust AI to manage data responsibly, using secure algorithms and access controls that prevent unauthorized use. This way, your research stays confidential while benefiting from AI’s analytical power, safeguarding patient data and research integrity.
Can AI Predict Long-Term Nanomedicine Effects Accurately?
Imagine the future of medicine as a beacon guiding you through uncertainty. AI, through advanced predictive modeling, can forecast the long-term effects of nanomedicine with increasing accuracy, helping you understand its efficacy over time. While no tool is perfect, AI’s efficacy forecasting improves as data accumulates, giving you a clearer picture of potential outcomes. Trust in this evolving technology to illuminate your path toward safer, more effective treatments.
What Are Emerging AI Tools for Nanomedicine Efficacy Assessment?
You should explore emerging AI tools that assess nanomedicine efficacy by analyzing nanomedicine biomarkers. These tools use advanced AI models validated through rigorous processes, ensuring reliable predictions. You’ll find that machine learning algorithms, especially deep learning, are increasingly being applied to interpret complex biomarker data. This integration helps you accurately evaluate treatment responses and enhances long-term efficacy assessments, making nanomedicine development more precise and effective.
Conclusion
By harnessing AI to track nanomedicine efficacy, you’re opening a gateway where innovation dances with precision. Think of it as illuminating a dark forest, revealing hidden pathways and unseen obstacles, guiding your journey toward breakthrough treatments. As algorithms become your compass, you navigate the complex terrain of healing with unwavering clarity. Embrace this synergy, and watch your efforts transform into a symphony of targeted, effective therapies that change the landscape of medicine itself.